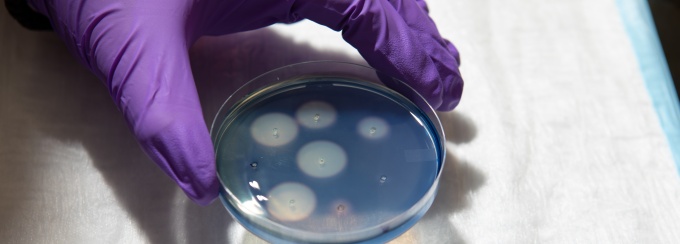
A gloved hand holding a pipette.

Welcome to the Ruhl Lab! Learn more about us below.
Stefan Ruhl, DDS, PhD, is an internationally known expert on oral biology. He researches saliva and oral bacteria, with the goal of elucidating the role they play in health. One area of focus is the development of tools for learning about glycans, biomolecules that help bacteria attach to host surfaces, including in the mouth. This project includes an effort to collect oral bacteria and saliva from humans, horses, cows, sheep, rodents and other mammals.
In other studies, Ruhl has investigated the evolutionary history of important salivary proteins. This work has led to important advances in the field, such as the identification of a starch-digesting enzyme called amylase in the saliva of pet dogs and various other mammals for the first time.
The International Association for Dental Research has recognized Ruhl's work and leadership in the field, naming him Salivary Researcher of the Year and honoring him with the association's Distinguished Scientist Award in Salivary Research. He was also elected a Fellow of the American Association for the Advancement of Science (AAAS), the American Association for Dental, Oral and Craniofacial Research (AADOCR) and the International College of Dentists (ICD).
Research in our laboratory focuses on the molecular mechanisms underlying initial bacterial attachment to teeth, tissue, or biomaterial surfaces in the mouth. We aim to elucidate the molecular mechanisms by which glycoproteins in saliva or on host cells are recognized by glycan-binding microbial adhesins. It is our long-term goal to better understand the modulating role of saliva in supporting colonization of the human oral cavity by a benign commensal microbiota and in host defense against pathogenic microorganisms. More recently, our research has involved investigating the evolutionary mechanisms that have shaped host-microbial interactions in the human mouth.
There are currently no opportunities available. Please check back soon.
Location: 646 Biomedical Research Building, Buffalo, NY 14214
Laboratory Phone Number: 716-829-6318